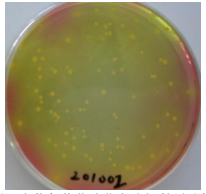
甘露醇氯化鈉瓊脂對照培養基

甘露醇氯化鈉瓊脂對照培養基分析證書(COA)
中文名稱:甘露醇氯化鈉瓊脂對照培養基
英文名稱:Mannitol Salt Agar Reference Medium ( MSARM )
批號:135007-201002
配方:參見 2010 版中國藥典。
外觀:本品為粉紅色均一粉末,加入水中混懸均勻,滅菌后熔化狀態為為紅色半透明液體。
裝量:本品標示裝量 33.3g/袋/300mL,平均裝量 33.26g/袋,RSD=0.03%(n=10,S=0.01g)。
酸度:本品滅菌后 pH 7.5,符合 2010 版中國藥典滅菌后 pH7.4±0.2 的規定。
生長能力:取 2010 版中國藥典收載的金黃色葡萄球菌 (Staphylococcus aureus)[CMCC(B) 26003],以 50-100cfu 接種至該批培養基,30-35℃培養 24 小時后,測試菌株均生長良好,菌落形態如下圖。
圖:金黃色葡萄球菌在該批甘露醇氯化鈉瓊脂對照培養基表面的生長形態。抑制能力:取 2010 版中國藥典收載的以下菌株,以 100-1000cfu 接種至該批培養基,30-35℃培養 72 小時后,測試菌株均未見生長。
銅綠假單胞菌 (Pseudomonas aeruginosa) [CMCC(B) 10104]
大腸埃希菌 (Escherichia coli) [CMCC(B) 44102]
該批對照培養基滿足 2010 年版《中國藥典》培養基適用性實驗的要求,可用于培養基適用性檢查對比實驗。
點擊查看→→產品價格